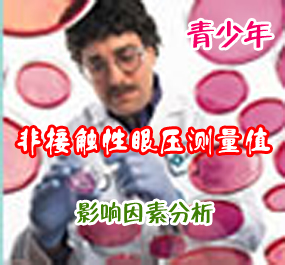

【摘要】 目的 研究青少年非接触性眼压计(non-contact tonometer,NCT)测量眼压值的影响因素。方法 门诊就诊青少年患者1132例(2264眼),测量双眼眼压值、眼球屈光度、角膜曲率、眼轴长度,所测得的数据采用SAS 8.2分析软件进行统计学分析,研究年龄、眼别、眼球屈光度、屈光状况(近视、正视、远视的分组情况)、角膜曲率、眼轴长度对青少年NCT测量值的影响。结果 在2264眼中,近视眼1822眼(占80.48%),正视眼152眼(占6.71%),远视眼290眼(占12.81%)。分别对右眼、左眼NCT测量值的影响因素进行多因素回归分析,右眼、左眼的屈光状况对NCT测量值的影响差异有统计学意义(分别为F=5.22,P=0.0057,β=0.4601;F=5.01,P=0.0069,β=0.4385);右、左眼资料合并后,采用Mix模型进行多因素回归分析,所有变量对NCT测量值均无影响。在单因素分析的基础上,引入年龄、眼别、性别、屈光状况变量,结果显示,年龄、眼别、屈光状况对NCT测量值存在影响,差异有统计学意义(分别为F=8.90,P=0.0029,β=0.0790;F=4.30,P=0.0384,β=0.1186;F=5.18,P=0.0072);右眼压平均为(15.4±2.8)mmHg,左眼压为(15.5±2.8)mmHg,差异没有统计学意义。近视组平均眼压为(15.52±0.08)mmHg,远视组为(15.22±0.20)mmHg,正视组为(14.91±0.18)mmHg,近视组与正视组的眼压值差异有统计学意义(F=3.16,P=0.0021,β=0.6116),而远视组与正视组的眼压值差异无统计学意义(F=1.35,P=0.1789,β=0.3065)。结论 随着年龄增长,青少年NCT测量值增高,患眼的屈光状况(远视、近视、正视)对NCT测量值的影响具有统计学意义,近视眼的NCT测量值较正视眼高。
【关键词】 非接触性眼压计;眼压;屈光状况;屈光度;角膜曲率;眼轴
眼压测量的临床意义十分重要,由于操作简便、无创性的优点,非接触性眼压计(non-contact tonometer,NCT)在各级医院被广泛应用,对于青少年患者多采用这种测量方法。我们分析了门诊就诊的青少年屈光不正患者NCT测量值的影响因素,现将结果报告如下,以期指导临床对青少年眼压的正确评估。
1 资料与方法
1.1 研究对象 选取2006年暑假及2007年寒假来我院验光的青少年患者1132例(2264眼),年龄7~18岁,平均(11.4±3.0)岁。其中,男性530例(1060眼,占46.8%),女性602例(1204眼,占53.2%)。所有入选对象均接受0.5%托吡卡胺扩瞳验光,且排除屈光不正以外的其他眼病。
1.2 检查方法
1.2.1 眼压的测量 采用日本Canon公司生产的Tonometer TX-10型NCT测量眼压。嘱咐患者取端坐位,调整升降台的高度,使患者舒适就座,避免过度弯腰、抬头,嘱咐患者下颌置于颌托上,额头紧贴额托带,再调整颌托高度,使眼位高度适于测量。测量前向患者交代气体喷出的情况,避免紧张,每眼测量3次,3次结果差距超过3 mmHg者重新测量,以保证测量的准确性。测量值取3次的平均值。
1.2.2 眼球屈光度的测量 测量前用0.5%托吡卡胺扩瞳,采用日本Topcon公司KR8800型自动验光仪(auto kerato-refractometer)测量,每眼测量3次,3次结果差距超过0.5 D球镜度数者重新测量,屈光度值自动取3次的平均值。以等效球镜度数进行分析。等效球镜度数的计算公式为:测量所得的球镜度数+1/2柱镜度数。将屈光状况按照如下标准对患者进行分组:近视组,等效球镜度数<-0.5 D;正视组,等效球镜度数为-0.5~0.5 D;远视组,等效球镜度数>0.5 D。
1.2.3 角膜曲率的测量 采用日本Topcon公司KR8800型自动验光仪(auto kerato-refractometer)测量,以屈光力(dioptric power,D)表示,曲率值自动取垂直及水平方向(K1、K2)的平均值,每眼测量3次,3次结果差距超过0.5 D者重新测量。结果分析时引进K1、K2中屈光力较大者的轴位进行分析,称为最大屈光力轴位。
1.2.4 眼轴长度的测量 采用德国Zeiss公司生产的IOL Master仪器进行无创性测量,每眼测量3次,取3次的平均值。
1.3 统计学方法 对所测得的数据采用SAS 8.2分析软件进行统计学分析,每例患者的左、右眼数值合并后采用Mix模型进行统计。定量数据单因素分析采用普通线性回归和成组比较的t检验,多因素分析采用多元线性回归法。
2 结果
在2264眼中,以等效球镜度数评判,近视眼1822眼(占80.48%),正视眼152眼(占6.71%),远视眼290眼(占12.81%);屈光不正眼占93.29%。
2.1 不同眼别的NCT眼压值、眼球屈光度、角膜曲率、最大屈光力轴位、眼轴长度的测量值 见表1。
2.2 右眼NCT测量值的影响因素分析 对影响右眼NCT测量值的各因素(年龄、屈光度、角膜曲率、最大屈光力轴位、眼轴)进行线性回归,性别、屈光状况的影响采用t检验分析,各影响因素结果见表2 。再将所有变量(年龄、性别、眼球的屈光度、角膜曲率、最大屈光力轴位、眼轴、屈光状况)进行多因素回归分析,结果发现,右眼的屈光状况对NCT测量值存在影响(F=5.22,P=0.0057,β=0.4601)。
2.3 左眼NCT测量值的影响因素分析 对影响左眼NCT测量值的各因素进行线性回归分析,各影响因素结果见表3。对所有变量进行多因素回归分析,也发现左眼的屈光状况对NCT测量值存在影响(F=5.01,P=0.0069,β=0.4385)。
2.4 双眼NCT测量值的多因素分析 将患者的左、右眼资料合并后,采用Mix模型对所有变量进行多因素回归分析,所有变量对NCT测量值均无影响。在单因素分析的基础上,引入年龄、眼别、性别、屈光状况变量,结果显示,年龄、眼别、屈光状况对NCT测量值存在影响,结果见表4。
继续将近视组、远视组分别与正视组的眼压进行比较,近视组平均眼压为(15.52±0.08)mmHg,远视组平均眼压为(15.22±0.20)mmHg,正视组平均眼压为(14.91±0.18)mmHg,近视组与正视组的眼压值存在差异(F=3.16,P=0.0021,β=0.6116),而远视组与正视组的眼压值无差异(F=1.35,P=0.1789,β=0.3065)。
3 讨论
3.1 门诊青少年NCT测量值的特点 门诊就诊的1132例屈光不正青少年患者的NCT测量值为:右眼NCT值范围为8.6~24.1 mmHg,左眼NCT值范围为8.6~25.3 mmHg。绝大部分接受检查的患眼NCT测量值均在正常统计学范围内,极少数NCT值超过24 mmHg,最高为25.3 mmHg。笔者发现,门诊有些青少年首次测量所得的NCT值较高,甚至超过30 mmHg,此时需谨慎对待这些“高眼压”。首先可进行解释以消除患者的紧张情绪,调整坐姿,重新测量时从上眶缘处将上眼睑拉起(不要压迫眼球),避免眼睫毛、眼睑产生的测量误差,真正高眼压症患者极少。如果再次测量所得NCT值仍高,则可改用Goldmann压平眼压计复测,进一步分析高眼压的原因,并进行相应处理。
3.2 青少年NCT测量值的影响因素分析
3.2.1 屈光状况 双眼资料合并后,采用Mix模型对所有变量进行多因素回归分析,所有变量对NCT测量值均无影响,其中屈光状况的影响可能有统计学意义(F=2.78,P=0.0707,β=0.6909),而且屈光状况与眼轴、眼球的屈光度、角膜曲率之间并非完全独立的影响因素,所以剔除这些因素后再进行多因素回归分析,患眼的屈光状况(远视、近视、正视)对NCT测量值的影响具有统计学意义。继续将近视组、远视组分别与正视组的眼压进行比较,近视组平均眼压为(15.52±0.08)mmHg,远视组平均眼压为(15.22±0.20)mmHg,正视组平均眼压为(14.91±0.18)mmHg,近视组与正视组的眼压值差异有统计学意义(F=3.16,P=0.0021,β=0.6116),而远视组与正视组的眼压值差异无统计学意义(F=1.35,P=0.1789,β=0.3065),这与其他学者的研究结果相似[1],近视眼的眼压测量值较高。有研究发现,近视度数越深,相应眼压值越高[2]。但是有研究表明[3],眼压测量时眼球壁的变形程度与球壁的材质特点及眼球壁的形态有关。球壁的材质特点主要指眼球壁的弹性度。近视眼患者尤其是高度近视眼,由于眼轴的延长、眼内容扩张,导致眼球壁抵抗力减弱、球壁硬度降低而使得眼压的测量值低于实际眼压值。因此,对于高度近视患者,如果眼压测量值偏高,应该进行细致的眼科检查,警惕是否发生青光眼。
3.2.2 年龄 本研究发现,青少年年龄对NCT测量值存在影响,差异有统计学意义,且随着年龄增长眼压测量值增高(F=8.90,P=0.0029,β=0.0790)。大多数的研究表明,眼压与年龄呈正相关[2,4],可能随着年龄的增长,血压升高,脉搏加快,肥胖发生,导致眼压测量值增高。临床中也观察到处于发育期的青少年眼压测量值处于较高状态。但是另外有研究认为两者没有相关性[4],甚至有研究[1]发现随着年龄的增长,眼压值反而下降。
3.2.3 眼别 本研究中分析眼别对NCT测量值的影响,差异有统计学意义(F=4.30,P=0.0384,β=0.1186),但是,从临床上分析可见,右眼压平均为(15.4±2.8)mmHg,左眼压为(15.5±2.8)mmHg,差异没有统计学意义。
3.2.4 角膜曲率 本研究还分析了角膜曲率对NCT测量值的影响,差异没有统计学意义。Shimmyo等[4]对不同种族人群(包括高加索人、亚洲人、西班牙人及非裔美国人)的角膜曲率、角膜厚度对眼压的影响进行研究,未发现角膜曲率具有种族差异性,即并非影响眼压的主要因素,但发现角膜曲率与厚度间有明显相关性。Lam等[5]的研究发现,患者采取坐位时,角膜曲率与眼压测量值之间没有相关性。有研究认为角膜越陡峭,眼压值越高,尽管差异有统计学意义,但是相关性较弱(r=0.1788),角膜曲率每增加1 D,眼压升高0.34 mmHg,而且该研究仅仅测量了角膜水平轴向的曲率值。Matsumoto等[6]认为角膜曲率越陡,导致角膜刚性越大,从而使得NCT测量值偏高。我国刘丽等[2]研究发现,角膜曲率越大,NCT测量值越高。
3.2.5 眼轴 有关眼轴长度对NCT测量值的影响,双眼资料合并后统计学分析没有意义。但是,分别对左、右眼进行分析时均发现,眼轴与NCT测量值呈正相关(?茁值分别为0.2166、0.1967),差异有统计学意义。从近视患眼的NCT测量值高于正视眼来看,近视多为轴性,即伴有眼轴的延长,可能眼轴并不是一个独立的影响因素,而是近视度数加深的一种表现。也有的学者[1]认为小儿患者中眼轴与眼压相关,可能提示眼压的升高导致眼轴的延长。
3.2.6 角膜厚度 目前有很多研究针对角膜厚度对眼压测量值的影响进行分析,认为角膜厚度是眼压的一个主要影响因素,因为本研究的对象均为门诊就诊的患屈光不正的青少年,角膜厚度测量配合度较差,所以此次研究没有引入角膜厚度这个变量。
【参考文献】 [1] Stamper RL, Lieberman MF, Drake MV. Becher-shaffer’s Diagnosis and Therapy of the Glaucomas[M]. 7th ed. St Louis: CV Mosby Co,2001:75-78.
[2] 刘丽,周跃华. 影响近视患者眼压测量值的多因素分析[J]. 眼科新进展,2006,26(2):133-136.
[3] Foster PJ, Wong JS, Wong E, et al. Accuracy of clinical estimates of intraocular pressure in Chinese eyes[J]. Ophthalmology,2000,107(10):1816-1821.
[4] Shimmyo M, Ross AJ, Moy A, et al. Intraocular pressure, Goldmann applanation tension,corneal thickness,and corneal curvature in Caucasians,Asians,Hispanics,and African Americans[J]. Am J Opthalmol,2003,136(4):603-613.
[5] Lam AK, Douthwaite WA. The effect of an artificially elevated intraocular pressure on the central corneal curvature[J]. Opththalmic Physiol Opt,1997,17(1):18-24.
[6] Matsumoto T, Makino H, Uozato H, et al. The influence of corneal thickness and curvature on the difference between intraocular pressure measurements obtained with a non-contact tonometer and those with a goldmann applanation tonometer[J]. Nippon Ganka Gakkai Zasshi,2000,104(5):317-323.
|